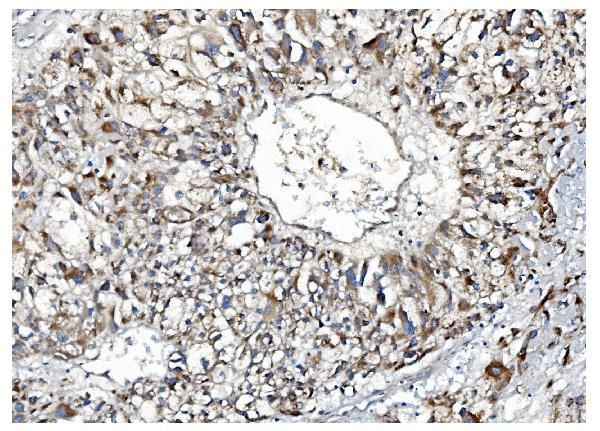
IDO2 Antibody in Immunohistochemistry (Paraffin) (IHC (P))

Search
Invitrogen
IDO2 Polyclonal Antibody
{{$productOrderCtrl.translations['antibody.pdp.commerceCard.promotion.promotions']}}
{{$productOrderCtrl.translations['antibody.pdp.commerceCard.promotion.viewpromo']}}
{{$productOrderCtrl.translations['antibody.pdp.commerceCard.promotion.promocode']}}: {{promo.promoCode}} {{promo.promoTitle}} {{promo.promoDescription}}. {{$productOrderCtrl.translations['antibody.pdp.commerceCard.promotion.learnmore']}}
图: 1 / 3
IDO2 Antibody (PA5-143950) in IHC (P)



产品信息
PA5-143950
种属反应
宿主/亚型
分类
类型
抗原
偶联物
形式
浓度
规格
纯化类型
保存液
内含物
保存条件
运输条件
RRID
产品详细信息
Adding 0.2 mL of distilled water will yield a concentration of 500 µg/mL.
Positive Control - WB: rat liver tissue, mouse liver tissue, monkey kidney tissue. IHC: human liver cancer tissue. Flow: K562 cell.|Store at -20°C for one year from date of receipt. After reconstitution, at 4°C for one month. It can also be aliquotted and stored frozen at -20°C for six months. Avoid repeated freeze-thaw cycles.
靶标信息
Along with the enzymes encoded by the INDO and TDO2 genes, the enzyme encoded by the INDOL1 gene metabolizes tryptophan in the kynurenine pathway.
仅用于科研。不用于诊断过程。未经明确授权不得转售。
篇参考文献 (0)
生物信息学
蛋白别名: 3-dioxygenase 2; 3-dioxygenase-like protein 1; EC 1.13.11.; IDO-2; INDOL 1; indoleamine 2; Indoleamine 2,3 dioxygenase 2; Indoleamine 2,3 dioxygenase like 1 protein; Indoleamine 2,3-dioxygenase 2; indoleamine 2,3-dioxygenase-like 1 protein; Indoleamine 2,3-dioxygenase-like protein 1; Indoleamine pyrrole 2,3 dioxygenase like 1; Indoleamine-pyrrole 2; indoleamine-pyrrole 2,3 dioxygenase-like 1; indoleamine-pyrrole 2,3-dioxygenase; Indoleamine-pyrrole 2,3-dioxygenase-like protein 1; unnamed protein product
基因别名: AI265623; C230043N17Rik; Ido-2; IDO2; INDOL1
UniProt ID: (Human) Q6ZQW0, (Rat) F1LV46, (Mouse) Q8R0V5
Entrez Gene ID: (Human) 169355, (Rat) 681319, (Mouse) 209176